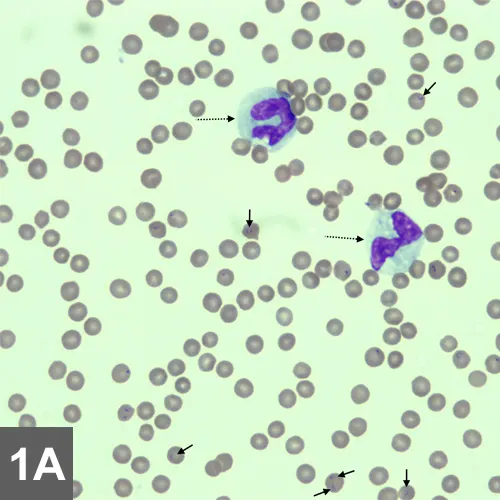
Featured Image
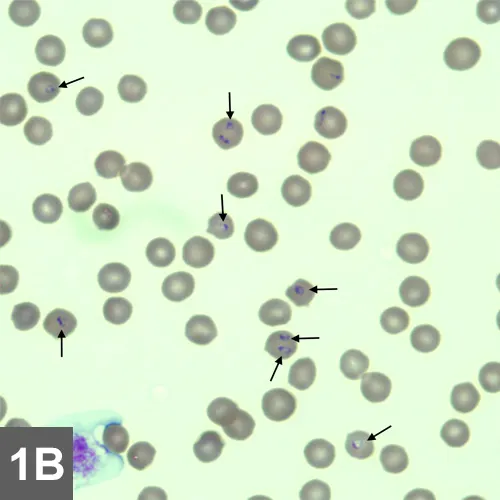
Cytology showing arrows pointing to small basophilic structures located within RBCs.
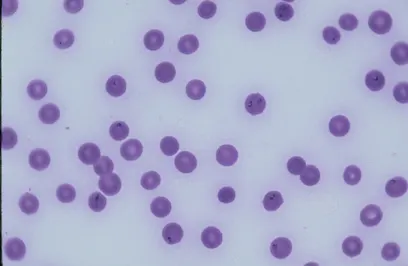
Cytology of RBCs with some containing small, dark-staining organisms.

Feline Cytauxzoonosis: Fatal Infection
Joanna K. Fry, DVM, Gulf Coast Veterinary Specialists
Derek P. Burney, DVM, PhD, DACVIM, Veterinary Specialists of North Texas

First identified in 1948, Cytauxzoon spp are protozoal hemoparasites of wild and domestic cats.
Profile
Definition
Cytauxzoon spp have been isolated and infections documented in several animals in the wild, including free-ranging bobcats, Florida panthers, and Texas cougars.1-5
C felis is associated with a rapid course of disease, high morbidity, and high mortality.
Recent studies have demonstrated that a small percentage of healthy cats are infected and may represent chronic carriers or a new reservoir.6-8
Cytauxzoon spp are classified as part of the family Theileriidae, which includes Babesia and Theileria organisms.9,10
Geographic Distribution
Cytauxzoonosis has been documented in south-central, southeastern, and mid-Atlantic regions of the United States.8,11,12
Disease has been confirmed in Kansas, Oklahoma, Missouri, Arkansas, Texas, Indiana, Kentucky, North Carolina, South Carolina, Mississippi, Louisiana, Georgia, and Virginia.6,8,9,11-18
Overall tick activity as well as the activity of ticks at different life stages vary by season and geographic location.
On average, peak exposure and case incidence occur in the late spring/early summer (April–June), with a smaller peak in late summer/early fall (August–September).19
Signalment
Males and females of all feline breeds and ages appear to be equally at risk.
Disease transmission requires exposure to and infestation of actively feeding ticks.
Risk Factors
Outdoor, feral, and free-ranging cats are at increased risk for exposure, particularly those with access to wooded environments where Dermacentor ticks are prevalent.
No association with FIV and/or FeLV status has been found.20
Currently, it is believed that C felis is not contagious between cats.
Cats within the same household, however, likely experience similar exposures and may be at increased risk for infection.18
Pathophysiology
Bobcats are considered reservoir hosts and are typically asymptomatic.
Erythroparasitemia has been noted.
A transient schizogony does occur in bobcats, but this phase is typically self-limiting and clinically insignificant.18
D variabilis and Amblyomma americanum are definitive hosts for C felis.
Transmission of the erythrocytic piroplasm via direct inoculation from parasitemic bobcats will result in a chronic asymptomatic carrier and clinically insignificant parasitemia.
Parasitemia does not confer protective immunity.
Exposure to the schizogonous phase in domestic cats can cause clinical disease and death.
Transmission via ingestion or inoculation of blood or tissue from infected bobcats is possible.
There are 2 distinct Cytauxzoon species forms: sporozoite and erythrocyte.
Tick vectors transmit the sporozoite form to the host.
After the sporozoite has entered endothelial-associated mononuclear cells, it undergoes asexual replication9; infected macrophages can become as large as 75 µm in diameter and can lead to circulatory impairment.
Asexual reproduction causes merozoites to rupture the host cell and infect additional mononuclear cells or erythrocytes.
The erythrocyte form or phase is referred to as a piroplasm and can be identified on peripheral blood smears (See Figure 1A).
Research has demonstrated that intraerythrocyte parasites can be visualized as early as 10 days postexperimental infection.
Most common form of C felis is a small round-to-oval signet-ring body measuring 1–5 µm (See Figure 1B), with a thick round nuclear area located peripherally.
The piroplasm can also undergo asexual reproduction and destroy RBCs, causing signs of hemolytic anemia; this mode of replication is significantly less pathogenic
Degree of erythroparasitemia varies throughout course of disease.
Blood film from a cat at 10¥ magnification. There is a moderate decrease in red cell mass (anemia) and thrombocytopenia. The leukocyte count is decreased, and neutrophils exhibit Döhle bodies and increased cytoplasmic basophilia and vacuolation consistent with moderate to marked toxic change (broken arrows). Small basophilic inclusions are present within erythrocytes (solid arrows). Courtesy of IDEXX Laboratories
Same blood film at higher magnification (40¥). Erythrocytes show several small signet-ring basophilic intracellular organisms consistent with Cytauxzoon organisms (arrows). Courtesy of IDEXX Laboratories
Why Piroplasm Replication is Less Pathogenic
The erythrocyte form, referred to as a piroplasm, often develops late in the course of disease, can vary in severity, and may not develop in some cases. Clinical signs of cytauxzoonosis are often due to the schizogonous phase, and schizont-laden macrophages can be found in any tissue throughout the body. The infected macrophages become enlarged and occlude the blood vessels, making this tissue form much more pathogenic.13
Signs
Clinical disease course is acute.18
Signs occur 5–14 days after exposure, and most cats die within 1 week of onset of signs.
Although signs are vague and nonspecific, lethargy, anorexia, dehydration, pallor, and icterus are common.
Temperatures >105°F (normal, 101.5°F–102.5°F) are common on presentation; resolution of fever and hypothermia can occur before death.
Generalized pain and reluctance to move can be common presentations, the cause of which is not well understood.
In more severely affected cats, lateral recumbency, neurologic abnormalities (ataxia, nystagmus), and coma are frequently noted.
Mesenteric lymphadenopathy has been reported but is not consistent.
Diagnosis
Definitive Diagnosis
Identification of organism in peripheral blood smears is necessary.
Giemsa or Romanowsky-based stains are ideal for differentiating C felis from other erythrocyte parasites (eg, Mycoplasma haemofelis), erythrocyte inclusions (eg, Howell-Jolly or Heinz bodies), and stain artifacts.13
Differentiation may be difficult early in disease course when erythroparasitemia is low, but marked increase in circulating organisms is noted as disease progresses.
If C felis is suspected, peripheral blood smears may be repeated q24h until organism is identified.
Piroplasms may be easily missed or misidentified.
Laboratory Findings
Common clinicopathologic abnormalities include nonregenerative anemia, leukopenia, and thrombocytopenia.18
Toxic changes to myeloid cell lines are also common.
Hyperbilirubinemia, hypoalbuminemia, and hyperglobulinemia are common late in disease course.6
Disseminated intravascular coagulation (DIC) may occur.
Imaging
Hepatosplenomegaly may be visible on abdominal radiographs.
Thoracic radiographs may reveal pulmonary changes consistent with edema, congestion, or consolidation.
Enlarged, tortuous pulmonary vessels may be present, and generalized cardiomegaly may be noted in cases of pericardial effusion.
Abdominal ultrasonography may disclose partial or complete occlusion of vascular beds.
Other Diagnostics
Cytology
Cytologic examination of spleen, lung, or kidney aspirates may be beneficial.
The schizont stage is characterized by a small, lobulated, ill-defined blue structure within the cell cytoplasm.
Organisms have also been found in lymph nodes, the liver, and bone marrow.
PCR Assay
PCR assay for C felis may be confirmatory in patients with low erythroparasitemia and has been used as a screening test to further define geographic distribution of C felis infection.
Histopathology
Postmortem histopathologic examination is often successful at identifying schizont-containing macrophages.
The characteristic histologic lesion of C felis is systemic venous distention with schizont-laden macrophages attached to the vascular endothelium13 (See Figure 2A).
Numerous small basophilic granules that represent the merozoite stage of the parasite are found within intracytoplasmic schizonts.
Affected macrophages become progressively larger, resulting in complete venous obstruction and thrombus formation.
Splenomegaly, and when present mesenteric lymphadenopathy, are early gross postmortem findings.
Erythrophagocytosis may be found within the splenic red pulp; a heavy parasite burden will be noted in lymph nodes within the macrophages, along with venous congestion.
Pulmonary edema, congestion, and consolidation are all possible pulmonary pathologies associated with C felis infection.
Petechial hemorrhage on the lung serosal surface and throughout the pulmonary interstitium is common.
Schizont-containing macrophages may be identified within the pulmonary venous system (See Figure 2B).
The Rare Recovery
Recovery has been documented in rare cases of naturally derived C felis infections, in which outcome did not depend on treatment.17
Persistent parasitemia is common in individuals that recover, and recurrence of clinical disease has not been reported.18
It is suspected that recovery is related to limited exposure to a virulent strain, a less virulent strain, or an atypical immunoresistance rather than response to medical therapy.
Individuals that recover from infection and remain persistently parasitemic may serve as an important reservoir.

Distended hepatic vein with luminal macrophages (magnification, 10x). Courtesy of IDEXX Laboratories

Same image at higher magnification (40x) shows schizont-laden macrophage (arrows) within the lumen of a hepatic vein in a cat diagnosed with Cytauxzoon felis infection. Courtesy of IDEXX Laboratories
Treatment
Inpatient
Medical treatment for cytauxzoonosis is controversial, as almost all infections are inevitably fatal.
If supportive treatment is elected, aggressive IV fluid therapy, blood transfusions, and heparin administration should be initiated to prevent DIC.
Medications
Various antiprotozoal agents have been administered in attempts to reduce morbidity and mortality associated with C felis infection; however, a standard of treatment has yet to be determined.
Atovaquone and azithromycin have shown the most promise as treatments for C felis infection.
Nutritional Management
Nutritional support is crucial.
Partial parenteral nutrition or enteral nutrition via nasogastric, esophagostomy, or percutaneous endoscopic gastrostomy tube may be necessary.
In General
Relative Cost
If hospitalized for aggressive supportive treatment: $$$$$
Follow-up care and testing: $$$
Cost Key
$ = <$100
$$ = $100-$250
$$$ = $250-$500
$$$$ = $500-$1,000
$$$$$ = >$1,000
(Actual costs will have regional variations)
Prognosis
Poor to grave.
Most C felis infections grow into rapidly progressive disease, with clinical signs developing within 2 weeks of infection.
Prevention
Most important route of infection is the tick vector, which becomes infected via bobcats and feral cats; implementing year-round tick prevention is key in reducing risk for infection.
Quick and effective tick removal and environmental control are recommended.
Limited outdoor exposure to prevent interaction with ticks, wild bobcats, or free-roaming cats is also recommended.
However, given that subclinical chronic carriers pose a threat and ingestion of the schizogonous phase can potentially result in fatal disease, risk for infection cannot be eliminated simply by implementing tick control.
Currently, no vaccine is available to prevent or control C felis infection.
Future Considerations
Prevalence of persistently infected but healthy individuals may provide insight into future treatment options or passive immunitymeasures.
Further evaluation of individuals that survive acute infection may hold promise in identifying the key component(s) to successful outcome.
Thoughts on Cytauxzoon felis
Cats were dying—and dying quickly. At first veterinarians thought they were dealing with hemobartonellosis, but postmortem examination revealed the disease was something quite different.
These cases, reported in 1976, dealt with adult cats dying after development of anemia, icterus, dehydration, and fever, followed by rapid progression to death and the finding of schizonts and merozoites in various tissues. Characteristic tissue phases of Cytauxzoon spp were found in samples from cats sent to University of Missouri.

Impression smear of the liver of an experimentally infected cat shows schizonts containing macrophages (arrows). Normal hepatocytes can also be seen (arrowhead).
Peripheral blood smear from a cat with cytauxzoonosis with piroplasms in several erythrocytes.
Within 6 years, this previously unrecognized disease had been reported not only in Missouri but also in numerous southeastern states. It was unknown whether the disease had been introduced only recently in the United States, represented new exposure of pet cats to wildlife parasites because of encroachment into wildlife habitats, or represented a change in virulence of the parasite.1,2 Because the first Cytauxzoon spp recognized were pathogens of ruminants in Africa, there was concern as to whether this disease represented a threat to food animals. A significant amount of work was done to determine the host range and pathogenicity of the parasite. After a variety of wildlife had been inoculated (as well as farm and laboratory animals) with whole blood from cats affected by terminal cytauxzoonosis, the organism was found to parasitize only domestic and wild cats, specifically bobcats.1,2 Early transmission studies typically were done by inoculating animals with peripheral blood or homogenates of spleen, lung, or lymph nodes from infected animals. Ticks serve as the natural vector for transmission of closely related organisms, and it was soon shown that Dermacentor variabilis was a competent vector of the disease. It has since been shown that Amblyomma americanum is also a competent vector and most likely the primary vector of C felis in nature.
The range of C felis follows that of the bobcat, and disease in cats has currently been identified in the south-central, southeastern, and mid-Atlantic United States. Research continues to determine why some cats survive this disease and others do not, in addition to developing advanced diagnostic techniques and determining the best treatment options.3
— Patricia Thomblison, DVM, MS (Parasitology)